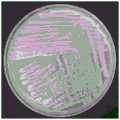

CN109679884B - A high-efficiency maize growth-promoting bacterium that can reduce nitrogen and phosphorus fertilizer application and its application - Google Patents
A high-efficiency maize growth-promoting bacterium that can reduce nitrogen and phosphorus fertilizer application and its applicationDownload PDFInfo
- Publication number
- CN109679884B CN109679884BCN201910150243.6ACN201910150243ACN109679884BCN 109679884 BCN109679884 BCN 109679884BCN 201910150243 ACN201910150243 ACN 201910150243ACN 109679884 BCN109679884 BCN 109679884B
- Authority
- CN
- China
- Prior art keywords
- corn
- bacillus
- promoting
- mgpr1
- growth
- Prior art date
- Legal status (The legal status is an assumption and is not a legal conclusion. Google has not performed a legal analysis and makes no representation as to the accuracy of the status listed.)
- Active
Links
- 240000008042Zea maysSpecies0.000titleclaimsabstractdescription60
- 235000002017Zea mays subsp maysNutrition0.000titleclaimsabstractdescription57
- IJGRMHOSHXDMSA-UHFFFAOYSA-NAtomic nitrogenChemical compoundN#NIJGRMHOSHXDMSA-UHFFFAOYSA-N0.000titleclaimsabstractdescription34
- OAICVXFJPJFONN-UHFFFAOYSA-NPhosphorusChemical compound[P]OAICVXFJPJFONN-UHFFFAOYSA-N0.000titleclaimsabstractdescription23
- 229910052698phosphorusInorganic materials0.000titleclaimsabstractdescription23
- 239000011574phosphorusSubstances0.000titleclaimsabstractdescription23
- 229910052757nitrogenInorganic materials0.000titleclaimsabstractdescription17
- 239000003337fertilizerSubstances0.000titleabstractdescription29
- 241000894006BacteriaSpecies0.000titleabstractdescription15
- 235000016383Zea mays subsp huehuetenangensisNutrition0.000titleabstractdescription7
- 235000009973maizeNutrition0.000titleabstractdescription7
- 235000005824Zea mays ssp. parviglumisNutrition0.000claimsabstractdescription50
- 235000005822cornNutrition0.000claimsabstractdescription50
- 241000194110Bacillus sp. (in: Bacteria)Species0.000claimsabstractdescription34
- 241000193830Bacillus <bacterium>Species0.000claimsabstractdescription28
- 239000002028BiomassSubstances0.000claimsabstractdescription10
- 229930002875chlorophyllNatural products0.000claimsabstractdescription5
- 235000019804chlorophyllNutrition0.000claimsabstractdescription5
- ATNHDLDRLWWWCB-AENOIHSZSA-Mchlorophyll aChemical compoundC1([C@@H](C(=O)OC)C(=O)C2=C3C)=C2N2C3=CC(C(CC)=C3C)=[N+]4C3=CC3=C(C=C)C(C)=C5N3[Mg-2]42[N+]2=C1[C@@H](CCC(=O)OC\C=C(/C)CCC[C@H](C)CCC[C@H](C)CCCC(C)C)[C@H](C)C2=C5ATNHDLDRLWWWCB-AENOIHSZSA-M0.000claimsabstractdescription5
- 238000004321preservationMethods0.000claimsabstractdescription4
- 238000009629microbiological cultureMethods0.000claimsabstract2
- 239000000243solutionSubstances0.000claimsdescription35
- 230000001580bacterial effectEffects0.000claimsdescription32
- 241000196324EmbryophytaSpecies0.000claimsdescription30
- 230000001737promoting effectEffects0.000claimsdescription29
- 239000007788liquidSubstances0.000claimsdescription24
- 239000002689soilSubstances0.000claimsdescription22
- XLYOFNOQVPJJNP-UHFFFAOYSA-NwaterSubstancesOXLYOFNOQVPJJNP-UHFFFAOYSA-N0.000claimsdescription22
- 235000013619trace mineralNutrition0.000claimsdescription18
- 239000011573trace mineralSubstances0.000claimsdescription18
- 238000011161developmentMethods0.000claimsdescription17
- 230000012010growthEffects0.000claimsdescription14
- DPXJVFZANSGRMM-UHFFFAOYSA-Nacetic acid;2,3,4,5,6-pentahydroxyhexanal;sodiumChemical compound[Na].CC(O)=O.OCC(O)C(O)C(O)C(O)C=ODPXJVFZANSGRMM-UHFFFAOYSA-N0.000claimsdescription12
- 239000001768carboxy methyl celluloseSubstances0.000claimsdescription12
- 238000000034methodMethods0.000claimsdescription12
- 235000019812sodium carboxymethyl celluloseNutrition0.000claimsdescription12
- 229920001027sodium carboxymethylcellulosePolymers0.000claimsdescription12
- 239000000618nitrogen fertilizerSubstances0.000claimsdescription8
- 239000003795chemical substances by applicationSubstances0.000claimsdescription6
- 238000002360preparation methodMethods0.000claimsdescription6
- 238000009331sowingMethods0.000claimsdescription6
- QIVBCDIJIAJPQS-VIFPVBQESA-NL-tryptophaneChemical compoundC1=CC=C2C(C[C@H](N)C(O)=O)=CNC2=C1QIVBCDIJIAJPQS-VIFPVBQESA-N0.000claimsdescription4
- QIVBCDIJIAJPQS-UHFFFAOYSA-NTryptophanNatural productsC1=CC=C2C(CC(N)C(O)=O)=CNC2=C1QIVBCDIJIAJPQS-UHFFFAOYSA-N0.000claimsdescription4
- 230000001965increasing effectEffects0.000claimsdescription4
- 239000004480active ingredientSubstances0.000claimsdescription3
- 239000002686phosphate fertilizerSubstances0.000claimsdescription3
- 239000007864aqueous solutionSubstances0.000claimsdescription2
- 239000011248coating agentSubstances0.000claimsdescription2
- 238000000576coating methodMethods0.000claimsdescription2
- 238000012258culturingMethods0.000claimsdescription2
- 238000010899nucleationMethods0.000claimsdescription2
- 208000012886VertigoDiseases0.000claims2
- 230000035800maturationEffects0.000claims2
- 238000009987spinningMethods0.000claims2
- 229910003562H2MoO4Inorganic materials0.000claims1
- 229910052927chalcanthiteInorganic materials0.000claims1
- 238000001035dryingMethods0.000claims1
- 239000007952growth promoterSubstances0.000claims1
- 229910000357manganese(II) sulfateInorganic materials0.000claims1
- 239000002068microbial inoculumSubstances0.000claims1
- 238000005507sprayingMethods0.000claims1
- 229910000368zinc sulfateInorganic materials0.000claims1
- 239000011686zinc sulphateSubstances0.000claims1
- 230000000813microbial effectEffects0.000abstractdescription17
- 230000004720fertilizationEffects0.000abstractdescription5
- 230000007812deficiencyEffects0.000abstractdescription3
- 230000009467reductionEffects0.000abstractdescription3
- 230000002195synergetic effectEffects0.000abstract1
- 239000002609mediumSubstances0.000description43
- 239000002054inoculumSubstances0.000description19
- FAPWRFPIFSIZLT-UHFFFAOYSA-MSodium chlorideChemical compound[Na+].[Cl-]FAPWRFPIFSIZLT-UHFFFAOYSA-M0.000description18
- 239000008367deionised waterSubstances0.000description13
- 229910021641deionized waterInorganic materials0.000description13
- 230000000694effectsEffects0.000description11
- 239000000589SiderophoreSubstances0.000description9
- 230000018109developmental processEffects0.000description9
- 239000011780sodium chlorideSubstances0.000description9
- 239000007787solidSubstances0.000description9
- 229920001817AgarPolymers0.000description8
- ZLMJMSJWJFRBEC-UHFFFAOYSA-NPotassiumChemical compound[K]ZLMJMSJWJFRBEC-UHFFFAOYSA-N0.000description8
- 239000008272agarSubstances0.000description8
- 230000008635plant growthEffects0.000description8
- 239000011591potassiumSubstances0.000description8
- 229910052700potassiumInorganic materials0.000description8
- 238000004519manufacturing processMethods0.000description7
- 10802000446516S ribosomal RNAProteins0.000description6
- WCUXLLCKKVVCTQ-UHFFFAOYSA-MPotassium chlorideChemical compound[Cl-].[K+]WCUXLLCKKVVCTQ-UHFFFAOYSA-M0.000description6
- 239000003513alkaliSubstances0.000description6
- 230000002949hemolytic effectEffects0.000description6
- 239000000463materialSubstances0.000description6
- 244000005700microbiomeSpecies0.000description6
- 239000000575pesticideSubstances0.000description6
- 239000002253acidSubstances0.000description5
- 238000010586diagramMethods0.000description5
- 235000013305foodNutrition0.000description5
- 206010059866Drug resistanceDiseases0.000description4
- VEXZGXHMUGYJMC-UHFFFAOYSA-NHydrochloric acidChemical compoundClVEXZGXHMUGYJMC-UHFFFAOYSA-N0.000description4
- XSQUKJJJFZCRTK-UHFFFAOYSA-NUreaChemical compoundNC(N)=OXSQUKJJJFZCRTK-UHFFFAOYSA-N0.000description4
- 230000015572biosynthetic processEffects0.000description4
- 238000004090dissolutionMethods0.000description4
- 238000002474experimental methodMethods0.000description4
- VLTRZXGMWDSKGL-UHFFFAOYSA-Nperchloric acidChemical compoundOCl(=O)(=O)=OVLTRZXGMWDSKGL-UHFFFAOYSA-N0.000description4
- 239000000843powderSubstances0.000description4
- 239000000047productSubstances0.000description4
- 238000012216screeningMethods0.000description4
- 238000012163sequencing techniqueMethods0.000description4
- 238000011282treatmentMethods0.000description4
- 240000004808Saccharomyces cerevisiaeSpecies0.000description3
- HEMHJVSKTPXQMS-UHFFFAOYSA-MSodium hydroxideChemical compound[OH-].[Na+]HEMHJVSKTPXQMS-UHFFFAOYSA-M0.000description3
- 238000012271agricultural productionMethods0.000description3
- 230000009286beneficial effectEffects0.000description3
- 239000006161blood agarSubstances0.000description3
- 229940041514candida albicans extractDrugs0.000description3
- 239000003153chemical reaction reagentSubstances0.000description3
- 230000006378damageEffects0.000description3
- 230000002950deficientEffects0.000description3
- 238000005516engineering processMethods0.000description3
- 239000000203mixtureSubstances0.000description3
- 235000015097nutrientsNutrition0.000description3
- 229920001223polyethylene glycolPolymers0.000description3
- 239000001103potassium chlorideSubstances0.000description3
- 235000011164potassium chlorideNutrition0.000description3
- 238000004451qualitative analysisMethods0.000description3
- 239000000126substanceSubstances0.000description3
- 239000000725suspensionSubstances0.000description3
- 238000003786synthesis reactionMethods0.000description3
- 238000012360testing methodMethods0.000description3
- 239000012138yeast extractSubstances0.000description3
- 108020004414DNAProteins0.000description2
- 208000035240Disease ResistanceDiseases0.000description2
- WQZGKKKJIJFFOK-GASJEMHNSA-NGlucoseNatural productsOC[C@H]1OC(O)[C@H](O)[C@@H](O)[C@@H]1OWQZGKKKJIJFFOK-GASJEMHNSA-N0.000description2
- 206010018910HaemolysisDiseases0.000description2
- 241001465754MetazoaSpecies0.000description2
- 239000008118PEG 6000Substances0.000description2
- 229920002584Polyethylene Glycol 6000Polymers0.000description2
- 229930006000SucroseNatural products0.000description2
- CZMRCDWAGMRECN-UGDNZRGBSA-NSucroseChemical compoundO[C@H]1[C@H](O)[C@@H](CO)O[C@@]1(CO)O[C@@H]1[C@H](O)[C@@H](O)[C@H](O)[C@@H](CO)O1CZMRCDWAGMRECN-UGDNZRGBSA-N0.000description2
- 241000607479Yersinia pestisSpecies0.000description2
- 244000052616bacterial pathogenSpecies0.000description2
- 239000002585baseSubstances0.000description2
- 239000004202carbamideSubstances0.000description2
- 239000000919ceramicSubstances0.000description2
- 238000010790dilutionMethods0.000description2
- 239000012895dilutionSubstances0.000description2
- 201000010099diseaseDiseases0.000description2
- 208000037265diseases, disorders, signs and symptomsDiseases0.000description2
- 239000000417fungicideSubstances0.000description2
- 239000008103glucoseSubstances0.000description2
- 239000003292glueSubstances0.000description2
- 230000008588hemolysisEffects0.000description2
- 239000002917insecticideSubstances0.000description2
- 230000006799invasive growth in response to glucose limitationEffects0.000description2
- 238000002955isolationMethods0.000description2
- 230000007774longtermEffects0.000description2
- 235000016709nutritionNutrition0.000description2
- 230000035764nutritionEffects0.000description2
- 239000008363phosphate bufferSubstances0.000description2
- 239000002504physiological saline solutionSubstances0.000description2
- 108090000623proteins and genesProteins0.000description2
- 150000003839saltsChemical class0.000description2
- 239000011734sodiumSubstances0.000description2
- 230000001954sterilising effectEffects0.000description2
- 238000004659sterilization and disinfectionMethods0.000description2
- 239000011550stock solutionSubstances0.000description2
- 239000000758substrateSubstances0.000description2
- 239000005720sucroseSubstances0.000description2
- 239000006228supernatantSubstances0.000description2
- 230000009885systemic effectEffects0.000description2
- IIZPXYDJLKNOIY-JXPKJXOSSA-N1-palmitoyl-2-arachidonoyl-sn-glycero-3-phosphocholineChemical compoundCCCCCCCCCCCCCCCC(=O)OC[C@H](COP([O-])(=O)OCC[N+](C)(C)C)OC(=O)CCC\C=C/C\C=C/C\C=C/C\C=C/CCCCCIIZPXYDJLKNOIY-JXPKJXOSSA-N0.000description1
- 239000005730AzoxystrobinSubstances0.000description1
- 241000194107Bacillus megateriumSpecies0.000description1
- 108020000946Bacterial DNAProteins0.000description1
- 235000017166Bambusa arundinaceaNutrition0.000description1
- 235000017491Bambusa tuldaNutrition0.000description1
- LZZYPRNAOMGNLH-UHFFFAOYSA-MCetrimonium bromideChemical compound[Br-].CCCCCCCCCCCCCCCC[N+](C)(C)CLZZYPRNAOMGNLH-UHFFFAOYSA-M0.000description1
- VYZAMTAEIAYCRO-UHFFFAOYSA-NChromiumChemical compound[Cr]VYZAMTAEIAYCRO-UHFFFAOYSA-N0.000description1
- FBPFZTCFMRRESA-KVTDHHQDSA-ND-MannitolChemical compoundOC[C@@H](O)[C@@H](O)[C@H](O)[C@H](O)COFBPFZTCFMRRESA-KVTDHHQDSA-N0.000description1
- 241000238631HexapodaSpecies0.000description1
- 239000005906ImidaclopridSubstances0.000description1
- 229910021578Iron(III) chlorideInorganic materials0.000description1
- 239000006142Luria-Bertani AgarSubstances0.000description1
- 102000004317LyasesHuman genes0.000description1
- 108090000856LyasesProteins0.000description1
- 229930195725MannitolNatural products0.000description1
- 238000012408PCR amplificationMethods0.000description1
- 239000001888PeptoneSubstances0.000description1
- 108010080698PeptonesProteins0.000description1
- 244000082204Phyllostachys viridisSpecies0.000description1
- 235000015334Phyllostachys viridisNutrition0.000description1
- 239000002202Polyethylene glycolSubstances0.000description1
- 240000001987Pyrus communisSpecies0.000description1
- 235000014443Pyrus communisNutrition0.000description1
- 241000589157RhizobialesSpecies0.000description1
- 229920002472StarchPolymers0.000description1
- 238000010521absorption reactionMethods0.000description1
- 230000004913activationEffects0.000description1
- 239000013543active substanceSubstances0.000description1
- DLHONNLASJQAHX-UHFFFAOYSA-Naluminum;potassium;oxygen(2-);silicon(4+)Chemical compound[O-2].[O-2].[O-2].[O-2].[O-2].[O-2].[O-2].[O-2].[Al+3].[Si+4].[Si+4].[Si+4].[K+]DLHONNLASJQAHX-UHFFFAOYSA-N0.000description1
- 230000003321amplificationEffects0.000description1
- 238000004458analytical methodMethods0.000description1
- 239000003242anti bacterial agentSubstances0.000description1
- 230000000844anti-bacterial effectEffects0.000description1
- 229940088710antibiotic agentDrugs0.000description1
- WFDXOXNFNRHQEC-GHRIWEEISA-NazoxystrobinChemical compoundCO\C=C(\C(=O)OC)C1=CC=CC=C1OC1=CC(OC=2C(=CC=CC=2)C#N)=NC=N1WFDXOXNFNRHQEC-GHRIWEEISA-N0.000description1
- 239000011425bambooSubstances0.000description1
- 239000007640basal mediumSubstances0.000description1
- 239000003181biological factorSubstances0.000description1
- 239000008280bloodSubstances0.000description1
- 210000004369bloodAnatomy0.000description1
- YYRMJZQKEFZXMX-UHFFFAOYSA-Ncalcium;phosphoric acidChemical group[Ca+2].OP(O)(O)=O.OP(O)(O)=OYYRMJZQKEFZXMX-UHFFFAOYSA-N0.000description1
- 229910052799carbonInorganic materials0.000description1
- 239000005018caseinSubstances0.000description1
- BECPQYXYKAMYBN-UHFFFAOYSA-Ncasein, tech.Chemical compoundNCCCCC(C(O)=O)N=C(O)C(CC(O)=O)N=C(O)C(CCC(O)=N)N=C(O)C(CC(C)C)N=C(O)C(CCC(O)=O)N=C(O)C(CC(O)=O)N=C(O)C(CCC(O)=O)N=C(O)C(C(C)O)N=C(O)C(CCC(O)=N)N=C(O)C(CCC(O)=N)N=C(O)C(CCC(O)=N)N=C(O)C(CCC(O)=O)N=C(O)C(CCC(O)=O)N=C(O)C(COP(O)(O)=O)N=C(O)C(CCC(O)=N)N=C(O)C(N)CC1=CC=CC=C1BECPQYXYKAMYBN-UHFFFAOYSA-N0.000description1
- 235000021240caseinsNutrition0.000description1
- 230000015556catabolic processEffects0.000description1
- 210000004027cellAnatomy0.000description1
- 235000013339cerealsNutrition0.000description1
- 238000006243chemical reactionMethods0.000description1
- 238000005056compactionMethods0.000description1
- 238000007796conventional methodMethods0.000description1
- 238000012136culture methodMethods0.000description1
- 238000006731degradation reactionMethods0.000description1
- 238000001514detection methodMethods0.000description1
- -1drought and floodSubstances0.000description1
- 239000003814drugSubstances0.000description1
- 238000005538encapsulationMethods0.000description1
- 230000007613environmental effectEffects0.000description1
- 238000000855fermentationMethods0.000description1
- 230000004151fermentationEffects0.000description1
- 210000003495flagellaAnatomy0.000description1
- 235000012055fruits and vegetablesNutrition0.000description1
- 230000000855fungicidal effectEffects0.000description1
- 125000001475halogen functional groupChemical group0.000description1
- 239000004009herbicideSubstances0.000description1
- 230000015784hyperosmotic salinity responseEffects0.000description1
- YWTYJOPNNQFBPC-UHFFFAOYSA-NimidaclopridChemical compound[O-][N+](=O)\N=C1/NCCN1CC1=CC=C(Cl)N=C1YWTYJOPNNQFBPC-UHFFFAOYSA-N0.000description1
- 229940056881imidaclopridDrugs0.000description1
- 230000006872improvementEffects0.000description1
- 230000001939inductive effectEffects0.000description1
- 238000011081inoculationMethods0.000description1
- RBTARNINKXHZNM-UHFFFAOYSA-Kiron trichlorideChemical compoundCl[Fe](Cl)ClRBTARNINKXHZNM-UHFFFAOYSA-K0.000description1
- 230000020673lateral root developmentEffects0.000description1
- 239000000787lecithinSubstances0.000description1
- 235000010445lecithinNutrition0.000description1
- 229940067606lecithinDrugs0.000description1
- 235000015073liquid stocksNutrition0.000description1
- 239000000594mannitolSubstances0.000description1
- 235000010355mannitolNutrition0.000description1
- 230000007246mechanismEffects0.000description1
- 230000002503metabolic effectEffects0.000description1
- 235000010755mineralNutrition0.000description1
- 239000011707mineralSubstances0.000description1
- 239000011259mixed solutionSubstances0.000description1
- 238000002156mixingMethods0.000description1
- 239000006865modified yma mediumSubstances0.000description1
- 239000013642negative controlSubstances0.000description1
- 238000003199nucleic acid amplification methodMethods0.000description1
- 239000002773nucleotideSubstances0.000description1
- 125000003729nucleotide groupChemical group0.000description1
- 230000020477pH reductionEffects0.000description1
- 238000012856packingMethods0.000description1
- 244000052769pathogenSpecies0.000description1
- 235000019319peptoneNutrition0.000description1
- 230000035790physiological processes and functionsEffects0.000description1
- 239000003375plant hormoneSubstances0.000description1
- 235000010958polyglycerol polyricinoleateNutrition0.000description1
- 239000013641positive controlSubstances0.000description1
- 108090000765processed proteins & peptidesProteins0.000description1
- 102000004196processed proteins & peptidesHuman genes0.000description1
- 239000003223protective agentSubstances0.000description1
- 235000018102proteinsNutrition0.000description1
- 102000004169proteins and genesHuman genes0.000description1
- 238000004445quantitative analysisMethods0.000description1
- 239000002994raw materialSubstances0.000description1
- 238000005067remediationMethods0.000description1
- 238000012827research and developmentMethods0.000description1
- 230000002786root growthEffects0.000description1
- 238000011076safety testMethods0.000description1
- 238000005070samplingMethods0.000description1
- 229930000044secondary metaboliteNatural products0.000description1
- 230000003248secreting effectEffects0.000description1
- 238000013207serial dilutionMethods0.000description1
- 238000005063solubilizationMethods0.000description1
- 230000007928solubilizationEffects0.000description1
- 230000003381solubilizing effectEffects0.000description1
- 238000002798spectrophotometry methodMethods0.000description1
- 239000007921spraySubstances0.000description1
- 239000008107starchSubstances0.000description1
- 235000019698starchNutrition0.000description1
- 239000002426superphosphateSubstances0.000description1
- 230000004083survival effectEffects0.000description1
- 230000002194synthesizing effectEffects0.000description1
- 238000013518transcriptionMethods0.000description1
- 230000035897transcriptionEffects0.000description1
- 239000012137tryptoneSubstances0.000description1
Images
Classifications
- C—CHEMISTRY; METALLURGY
- C12—BIOCHEMISTRY; BEER; SPIRITS; WINE; VINEGAR; MICROBIOLOGY; ENZYMOLOGY; MUTATION OR GENETIC ENGINEERING
- C12N—MICROORGANISMS OR ENZYMES; COMPOSITIONS THEREOF; PROPAGATING, PRESERVING, OR MAINTAINING MICROORGANISMS; MUTATION OR GENETIC ENGINEERING; CULTURE MEDIA
- C12N1/00—Microorganisms, e.g. protozoa; Compositions thereof; Processes of propagating, maintaining or preserving microorganisms or compositions thereof; Processes of preparing or isolating a composition containing a microorganism; Culture media therefor
- C12N1/20—Bacteria; Culture media therefor
- C12N1/205—Bacterial isolates
- C—CHEMISTRY; METALLURGY
- C12—BIOCHEMISTRY; BEER; SPIRITS; WINE; VINEGAR; MICROBIOLOGY; ENZYMOLOGY; MUTATION OR GENETIC ENGINEERING
- C12R—INDEXING SCHEME ASSOCIATED WITH SUBCLASSES C12C - C12Q, RELATING TO MICROORGANISMS
- C12R2001/00—Microorganisms ; Processes using microorganisms
- C12R2001/01—Bacteria or Actinomycetales ; using bacteria or Actinomycetales
- C12R2001/07—Bacillus
- A—HUMAN NECESSITIES
- A01—AGRICULTURE; FORESTRY; ANIMAL HUSBANDRY; HUNTING; TRAPPING; FISHING
- A01C—PLANTING; SOWING; FERTILISING
- A01C1/00—Apparatus, or methods of use thereof, for testing or treating seed, roots, or the like, prior to sowing or planting
- A01C1/06—Coating or dressing seed
- A—HUMAN NECESSITIES
- A01—AGRICULTURE; FORESTRY; ANIMAL HUSBANDRY; HUNTING; TRAPPING; FISHING
- A01N—PRESERVATION OF BODIES OF HUMANS OR ANIMALS OR PLANTS OR PARTS THEREOF; BIOCIDES, e.g. AS DISINFECTANTS, AS PESTICIDES OR AS HERBICIDES; PEST REPELLANTS OR ATTRACTANTS; PLANT GROWTH REGULATORS
- A01N63/00—Biocides, pest repellants or attractants, or plant growth regulators containing microorganisms, viruses, microbial fungi, animals or substances produced by, or obtained from, microorganisms, viruses, microbial fungi or animals, e.g. enzymes or fermentates
- C—CHEMISTRY; METALLURGY
- C05—FERTILISERS; MANUFACTURE THEREOF
- C05F—ORGANIC FERTILISERS NOT COVERED BY SUBCLASSES C05B, C05C, e.g. FERTILISERS FROM WASTE OR REFUSE
- C05F11/00—Other organic fertilisers
- C05F11/08—Organic fertilisers containing added bacterial cultures, mycelia or the like
- C—CHEMISTRY; METALLURGY
- C12—BIOCHEMISTRY; BEER; SPIRITS; WINE; VINEGAR; MICROBIOLOGY; ENZYMOLOGY; MUTATION OR GENETIC ENGINEERING
- C12N—MICROORGANISMS OR ENZYMES; COMPOSITIONS THEREOF; PROPAGATING, PRESERVING, OR MAINTAINING MICROORGANISMS; MUTATION OR GENETIC ENGINEERING; CULTURE MEDIA
- C12N1/00—Microorganisms, e.g. protozoa; Compositions thereof; Processes of propagating, maintaining or preserving microorganisms or compositions thereof; Processes of preparing or isolating a composition containing a microorganism; Culture media therefor
- C12N1/20—Bacteria; Culture media therefor
- Y—GENERAL TAGGING OF NEW TECHNOLOGICAL DEVELOPMENTS; GENERAL TAGGING OF CROSS-SECTIONAL TECHNOLOGIES SPANNING OVER SEVERAL SECTIONS OF THE IPC; TECHNICAL SUBJECTS COVERED BY FORMER USPC CROSS-REFERENCE ART COLLECTIONS [XRACs] AND DIGESTS
- Y02—TECHNOLOGIES OR APPLICATIONS FOR MITIGATION OR ADAPTATION AGAINST CLIMATE CHANGE
- Y02P—CLIMATE CHANGE MITIGATION TECHNOLOGIES IN THE PRODUCTION OR PROCESSING OF GOODS
- Y02P60/00—Technologies relating to agriculture, livestock or agroalimentary industries
- Y02P60/20—Reduction of greenhouse gas [GHG] emissions in agriculture, e.g. CO2
- Y02P60/21—Dinitrogen oxide [N2O], e.g. using aquaponics, hydroponics or efficiency measures
Landscapes
- Life Sciences & Earth Sciences (AREA)
- Chemical & Material Sciences (AREA)
- Health & Medical Sciences (AREA)
- Engineering & Computer Science (AREA)
- Organic Chemistry (AREA)
- Zoology (AREA)
- Wood Science & Technology (AREA)
- Bioinformatics & Cheminformatics (AREA)
- Biotechnology (AREA)
- Genetics & Genomics (AREA)
- General Health & Medical Sciences (AREA)
- Biochemistry (AREA)
- Microbiology (AREA)
- Virology (AREA)
- General Engineering & Computer Science (AREA)
- Medicinal Chemistry (AREA)
- Tropical Medicine & Parasitology (AREA)
- Biomedical Technology (AREA)
- Environmental Sciences (AREA)
- Agronomy & Crop Science (AREA)
- Pest Control & Pesticides (AREA)
- Plant Pathology (AREA)
- Dentistry (AREA)
- Soil Sciences (AREA)
- Micro-Organisms Or Cultivation Processes Thereof (AREA)
- Fertilizers (AREA)
Abstract
Description
Translated fromChinese技术领域technical field
本发明涉及微生物领域,具体涉及一株能减少氮磷肥施用的玉米高效促生菌及其应用。The invention relates to the field of microorganisms, in particular to a corn high-efficiency growth-promoting bacterium capable of reducing the application of nitrogen and phosphorus fertilizers and its application.
背景技术Background technique
我国农业生产中肥料施用量大但利用率不高且流失严重。化肥的长期过量施用对土壤也造成了一定的损伤,如土壤板结、酸化、盐碱化、微生物群体结构的破坏(有益微生物的减少,有害微生物的增多)等一系列问题,对食品安全也造成了一定的威胁。那么如何有效解决这些我国农业生产障碍问题和实现农业的可持续性发展?这正好与微生物肥料的功能相吻合,也正是微生物肥料的特点和专长。微生物肥料是实现我国农业绿色发展不可或缺的产品,我国比世界任何国家都更需要发展微生物肥料。In my country's agricultural production, the amount of fertilizer application is large, but the utilization rate is not high and the loss is serious. The long-term excessive application of chemical fertilizers has also caused certain damage to the soil, such as soil compaction, acidification, salinization, destruction of microbial community structure (reduction of beneficial microorganisms, increase of harmful microorganisms) and a series of problems, which also cause food safety. a certain threat. So how to effectively solve these obstacles to agricultural production in our country and achieve sustainable development of agriculture? This just coincides with the function of microbial fertilizers, and it is also the characteristics and expertise of microbial fertilizers. Microbial fertilizer is an indispensable product for realizing the green development of my country's agriculture. my country needs to develop microbial fertilizer more than any country in the world.
根据功能将微生物肥料划分为很多类型,促进农作物生长和产量的微生物肥通常由植物根际促生菌(plant growth promoting rhizobacteria,PGPR)构成。PGPR是指自由生活在土壤或附生于植物根系的一类可促进植物生长及其对矿质营养的吸收和利用,并能抑制有害生物的有益菌类。更重要的是有些PGPR能够诱导植物产生系统抗性(inducedsystemic resistance,ISR),从而提高植物整体的抗病能力。其与植物的促生关系分为直接作用和间接作用。直接作用主要表现为:(1)PGPR可以通过自身固氮、溶磷、解钾或产生铁载体直接供给植物营养;(2)PGPR可形成植物激素、次生代谢产物和裂解酶等促进根毛形成、横向根的发育和主根生长进而促进植物生长;(3)PGPR可诱导植物根细胞中的基因转录和代谢合成,改善根系生理机能。间接作用常指生物防治作用,包括抗病和抗虫,抗病作用主要表现为:(1)PGPR通过分泌抗生素、抗菌蛋白或多肽等活性物质杀死病原菌;(2)PGPR通过与病原菌争夺营养和生态位产生拮抗作用;(3)PGPR通过信号物质诱导植物获得系统抗性等而减轻病菌的危害。抗虫作用是通过产生挥发性物质趋避害虫或吸引害虫天敌起到抗虫作用。此外,PGPR还有抗逆(盐碱、旱涝、农药、营养胁迫等)和污染土壤修复等作用。Microbial fertilizers are classified into many types according to their functions. Microbial fertilizers that promote crop growth and yield are usually composed of plant growth promoting rhizobacteria (PGPR). PGPR refers to a type of beneficial bacteria that live freely in soil or epiphyte on plant roots, which can promote plant growth and its absorption and utilization of mineral nutrients, and can inhibit harmful organisms. More importantly, some PGPRs can induce systemic resistance (ISR) in plants, thereby improving the overall disease resistance of plants. Its growth-promoting relationship with plants can be divided into direct effect and indirect effect. The direct effects are mainly as follows: (1) PGPR can directly supply plant nutrients through its own nitrogen fixation, phosphorus dissolution, potassium dissolution or production of siderophore; (2) PGPR can form plant hormones, secondary metabolites and lyases to promote root hair formation, Lateral root development and tap root growth promote plant growth; (3) PGPR can induce gene transcription and metabolic synthesis in plant root cells and improve root physiological function. Indirect effects often refer to biological control effects, including disease resistance and insect resistance. The anti-disease effects are mainly as follows: (1) PGPR kills pathogenic bacteria by secreting active substances such as antibiotics, antibacterial proteins or peptides; (2) PGPR competes with pathogenic bacteria for nutrients (3) PGPR reduces the damage of pathogens by inducing plant to acquire systemic resistance through signal substances. The anti-insect effect is to avoid pests or attract natural enemies of pests by producing volatile substances. In addition, PGPR also has the effects of stress resistance (saline-alkali, drought and flood, pesticides, nutrient stress, etc.) and contaminated soil remediation.
尽管PGPR作用如此广泛,但其在大田应用中会受到多重因素的影响,如气候、土壤类型、土壤管理措施等非生物因子的干扰和植物基因型、植物不同发育阶段以及植物自身防御机制等生物因子的影响。这两大类因素都是影响PGPR应用效果的重要原因,因此应针对不同环境和植物类型筛选适合的微生物菌剂。虽然我国微生物肥料品种众多,但主要开发和应用对象都是瓜果蔬菜等经济价值较高的植物,适合于粮食作物的极少,适合玉米的就更少,加之现有的生物肥料成本高等原因,实际在玉米种植中农户根本用不起。因此,选育经济性好、适合我国东北地区的玉米高效微生物菌剂和耦合的应用技术,以达到减肥增效的目标,对于促进玉米农业绿色可持续发展十分必要和迫切。Although the role of PGPR is so extensive, its application in the field will be affected by multiple factors, such as the interference of abiotic factors such as climate, soil type, and soil management measures, and biological factors such as plant genotype, different developmental stages of plants, and plant self-defense mechanisms. factor influence. These two categories of factors are important factors that affect the application effect of PGPR. Therefore, suitable microbial inoculants should be screened for different environments and plant types. Although there are many varieties of microbial fertilizers in my country, the main targets for development and application are plants with high economic value such as fruits and vegetables. Very few are suitable for food crops, and even less are suitable for corn. In addition, the existing biological fertilizers have high costs. , in fact, farmers can't afford it at all in corn cultivation. Therefore, it is necessary and urgent to select and breed high-efficiency microbial inoculants and coupled application technologies for corn that are economical and suitable for Northeast my country in order to achieve the goal of losing weight and increasing efficiency.
发明内容SUMMARY OF THE INVENTION
本发明的目的是提供一种能减少氮磷肥施用的玉米高效促生菌及其应用。The purpose of the present invention is to provide a corn high-efficiency growth-promoting bacteria and its application which can reduce the application of nitrogen and phosphorus fertilizers.
第一方面,本发明要求保护一种芽孢杆菌。In a first aspect, the present invention claims a Bacillus.
本发明所要求保护的芽孢杆菌具体为芽孢杆菌(Bacillus sp.)MGPR1,其在中国普通微生物菌种保藏管理中心的保藏编号为CGMCC No.17040。The Bacillus claimed in the present invention is specifically Bacillus sp. MGPR1, whose deposit number in the China General Microorganism Culture Collection and Management Center is CGMCC No.17040.
本发明所述芽孢杆菌(Bacillus sp.)MGPR1经血琼脂平板培养法检测,溶血活性为阴性,表明对人畜无害。The Bacillus sp. MGPR1 of the present invention is detected by the blood agar plate culture method, and the hemolytic activity is negative, indicating that it is harmless to humans and animals.
本发明所述芽孢杆菌(Bacillus sp.)MGPR1经鉴定具有多种功能特征,主要包括:(1)促生功能:产IAA能力,IAA合成量为58.03μg/ml;具有解钾能力,可溶性解钾指数为2.34;具有产铁载体能力,可溶性指数为1.41。(2)抗逆性:可耐盐7%;耐酸pH5;耐碱pH10;耐干旱(30%PEG,重度干旱)。(3)耐药性:可耐受农业应用中普遍使用的杀虫剂吡虫啉(88ppm)和杀菌剂嘧菌酯(312.5ppm)的最大使用剂量。The Bacillus sp. MGPR1 of the present invention has been identified to have various functional characteristics, mainly including: (1) Growth-promoting function: IAA production capacity, IAA synthesis amount is 58.03 μg/ml; The potassium index is 2.34; it has the ability to produce siderophores, and the solubility index is 1.41. (2) Stress resistance: 7% salt resistance; acid resistance pH5; alkali resistance pH10; drought resistance (30% PEG, severe drought). (3) Drug resistance: It can tolerate the maximum dosage of insecticide imidacloprid (88ppm) and fungicide azoxystrobin (312.5ppm) commonly used in agricultural applications.
第二方面,本发明要求保护一种菌剂。In the second aspect, the present invention claims a bacterial agent.
本发明所要求保护的菌剂具体为活性成分为所述芽孢杆菌(Bacillus sp.)MGPR1的菌剂。The inoculum claimed in the present invention is specifically an inoculum whose active ingredient is the Bacillus sp. MGPR1.
所述菌剂中除了含有作为活性成分的所述芽孢杆菌(Bacillus sp.)MGPR1外,还含有辅料。所述辅料可根据需要选择。In addition to the Bacillus sp. MGPR1 as an active ingredient, the inoculum also contains auxiliary materials. The auxiliary materials can be selected according to needs.
在本发明的一个实施例中,所述菌剂具体为液体菌剂,是通过采用添加有终浓度为0.1mg/ml的色氨酸的LB液体培养基培养所述芽孢杆菌(Bacillus sp.)MGPR1获得的;所述芽孢杆菌(Bacillus sp.)MGPR1在所述液体菌剂中的浓度为1×1010-11cfu/ml。In one embodiment of the present invention, the inoculum is specifically a liquid inoculum, and the Bacillus sp. MGPR1; the concentration of the Bacillus sp. MGPR1 in the liquid inoculum is 1×1010-11 cfu/ml.
第三方面,本发明要求保护所述芽孢杆菌(Bacillus sp.)MGPR1在作为植物根际促生菌中的应用。In the third aspect, the present invention claims to protect the application of the Bacillus sp. MGPR1 as a plant rhizosphere growth-promoting bacteria.
第四方面,本发明要求保护所述芽孢杆菌(Bacillus sp.)MGPR1或所述菌剂在制备用于促进植物生长的产品中的应用。In a fourth aspect, the present invention claims the use of the Bacillus sp. MGPR1 or the inoculum in the preparation of a product for promoting plant growth.
其中,所述产品可为微生物肥料。Wherein, the product can be a microbial fertilizer.
第五方面,本发明要求保护所述芽孢杆菌(Bacillus sp.)MGPR1的田间应用方法。In the fifth aspect, the present invention claims a field application method of the Bacillus sp. MGPR1.
本发明所要求保护的所述芽孢杆菌(Bacillus sp.)MGPR1的田间应用方法,可包括如下步骤:The field application method of the Bacillus sp. MGPR1 claimed in the present invention may include the following steps:
(A1)向所述芽孢杆菌(Bacillus sp.)MGPR1的菌液中添加微量元素;(A1) adding trace elements to the bacterial solution of the Bacillus sp. MGPR1;
(A2)将步骤(A1)获得的添加有微量元素的菌液喷洒于植物种子表面,阴干;(A2) the bacterial liquid that step (A1) obtains and is added with trace elements is sprayed on the surface of plant seeds, dried in the shade;
(A3)步骤(A2)阴干的种子,用1%的羧甲基纤维素钠溶液再拌种包衣,阴干;(A3) The seeds dried in the shade of step (A2) are then coated with 1% sodium carboxymethyl cellulose solution, and dried in the shade;
(A4)播种。(A4) Seeding.
进一步地,步骤(A1)中,所述芽孢杆菌(Bacillus sp.)MGPR1的菌液可通过采用添加有终浓度为0.1mg/ml的色氨酸的LB液体培养基培养所述芽孢杆菌(Bacillus sp.)MGPR1获得;所述芽孢杆菌(Bacillus sp.)MGPR1在所述菌液中的浓度可为1×1010-11cfu/ml。其中,色氨酸为合成IAA的底物。Further, in step (A1), the bacterial solution of the Bacillus sp. MGPR1 can be used to culture the Bacillus sp. sp.) MGPR1; the concentration of the Bacillus sp. MGPR1 in the bacterial solution can be 1×1010-11 cfu/ml. Among them, tryptophan is the substrate for the synthesis of IAA.
进一步地,步骤(A1)中,所述微量元素可以微量元素溶液的形式添加到所述菌液中;所述微量元素液的组成可如下:H3BO3 2.86g/L,MnSO4 1.81g/L,CuSO4·5H2O0.80g/L,ZnSO4 0.22g/L,H2MoO4 0.02g/L,余量为水;向所述菌液中添加的所述微量元素液的量可为每mL所述菌液添加1μL所述微量元素液。其中,所述微量元素的作用是增加营养提高细菌活性。Further, in step (A1), the trace elements can be added to the bacterial liquid in the form of trace element solution; the composition of the trace element liquid can be as follows: H3 BO3 2.86g/L, MnSO4 1.81g /L, CuSO4 ·5H2 O 0.80g/L, ZnSO4 0.22g/L, H2 MoO4 0.02g/L, the balance is water; the amount of the trace element liquid added to the bacterial liquid 1 μL of the trace element solution can be added per mL of the bacterial solution. Wherein, the function of the trace element is to increase nutrition and improve bacterial activity.
进一步地,步骤(A2)中,所述添加有微量元素的菌液的用量以使种子表面湿润即可。Further, in step (A2), the amount of the bacterial liquid added with trace elements can be used to wet the surface of the seeds.
进一步地,步骤(A3)中,所述1%的羧甲基纤维素钠溶液为含有终浓度为10g/L羧甲基纤维素钠的水溶液。配制方法如下:10g羧甲基纤维素钠(800~1200mPa·s)溶于1L去离子水,在60℃水浴中搅拌溶解至透明糊状胶液。所述1%的羧甲基纤维素钠溶液的用量可为每kg种子用50mL(保持菌剂附着和湿度)。Further, in step (A3), the 1% sodium carboxymethyl cellulose solution is an aqueous solution containing a final concentration of 10 g/L sodium carboxymethyl cellulose. The preparation method is as follows: 10 g of sodium carboxymethyl cellulose (800-1200 mPa·s) is dissolved in 1 L of deionized water, stirred and dissolved in a water bath at 60° C. to a transparent paste-like glue. The dosage of the 1% sodium carboxymethyl cellulose solution can be 50 mL per kg of seeds (to keep the inoculum attached and humidity).
进一步地,步骤(A4)中,在进行完所述播种后还可包括浇水的步骤(保证菌株必要的湿度利于生存)。Further, in step (A4), after the sowing is completed, a watering step (to ensure the necessary humidity of the strain is conducive to survival) may also be included.
第六方面,本发明要求保护所述芽孢杆菌(Bacillus sp.)MGPR1或所述菌剂或第五方面中所述的方法在促进植物生长中的应用。In the sixth aspect, the present invention claims the application of the Bacillus sp. MGPR1 or the inoculum or the method described in the fifth aspect in promoting plant growth.
在上述各方面中,所述促进植物生长可体现为在氮胁迫和/或磷胁迫的土壤中促进植物生长。在本发明的一个实施例中,所述氮胁迫和/或磷胁迫的土壤具体为我国东北地区(如吉林省,具体如吉林省四平市梨树县三棵树村)的土壤。In each of the above aspects, the promoting plant growth may be embodied in promoting plant growth in nitrogen-stressed and/or phosphorus-stressed soil. In one embodiment of the present invention, the nitrogen-stressed and/or phosphorus-stressed soil is specifically the soil of Northeast China (such as Jilin Province, specifically, Sankeshu Village, Lishu County, Siping City, Jilin Province).
进一步地,所述氮胁迫是氮肥施用量为正常施用量的一半;所述磷胁迫是不施用磷肥。在本发明中,所述氮肥具体为尿素。Further, the nitrogen stress is that the nitrogen fertilizer application rate is half of the normal application amount; the phosphorus stress is that no phosphorus fertilizer is applied. In the present invention, the nitrogen fertilizer is specifically urea.
在上述各方面中,所述植物可为粮食作物。在本发明的一个实施例中,所述植物具体为玉米(如郑单958)。In each of the above aspects, the plant may be a food crop. In one embodiment of the present invention, the plant is specifically corn (eg, Zheng Dan 958).
在本发明中,所述促进植物生长具体可体现为如下中的全部或部分:In the present invention, the promotion of plant growth can be embodied in all or part of the following:
(B1)在所述植物的不同发育时期促进所述植物的株高增加;(B1) promoting the increase in plant height of the plant at different developmental stages of the plant;
(B2)在所述植物的不同发育时期促进所述植物的地上和/或地下生物量增加;(B2) promoting an increase in above-ground and/or below-ground biomass of said plant at different developmental stages of said plant;
(B3)在所述植物的不同发育时期促进所述植物的叶绿素含量增加;(B3) promoting the increase of the chlorophyll content of the plant at different developmental stages of the plant;
(B4)在所述植物的不同发育时期促进所述植物的叶面积指数增加;(B4) promoting an increase in the leaf area index of the plant at different developmental stages of the plant;
(B5)促进所述植物的百粒重增加;(B5) promoting the 100-grain weight increase of the plant;
(B6)促进所述植物的穗粒数增加;(B6) promoting the increase in the number of grains per ear of the plant;
(B7)促进所述植物的产量增加;(B7) promoting the yield increase of the plant;
所述不同发育时期为如下中的任一种:苗期(出苗后25天)、拔节期(出苗后50天)、吐丝期(出苗后75天)、成熟期(出苗后150天)。The different developmental stages are any of the following: seedling stage (25 days after emergence), jointing stage (50 days after emergence), silking stage (75 days after emergence), and mature stage (150 days after emergence).
本发明菌株芽孢杆菌(Bacillus sp.)MGPR1分离自玉米根际土壤,该菌株具有多种促生特性如高产IAA,解钾,产铁载体等,并具有很强的适应性如耐干旱、耐受农药和耐酸碱等,是生物安全菌株。在减氮肥施用50%和减磷肥施用100%的情况下,田间施用该菌剂比未施用对照可显著增加不同发育时期的玉米株高、地上及地下生物量、叶绿素、叶面积指数,玉米产量分别提高了12.56%和7.73%,且产量水平与正常施肥的水平无显著差异。本发明为我国玉米主要种植区—东北地区提供了高效稳定促生的微生物种质资源,有利于促进我国农业绿色健康可持续发展。利用此菌,可减少氮肥的投入和减轻过量施用氮肥对环境造成的污染,符合我国可持续绿色农业发展的需要和低碳、环保、生态农业的要求。该发明专利扩大了我国粮食作物促生菌种质资源,为研发高效稳定的微生物肥料以及应用技术提供基础。The strain Bacillus sp. MGPR1 of the present invention is isolated from corn rhizosphere soil, the strain has various growth-promoting properties such as high yield of IAA, potassium solubilization, siderophore production, etc., and has strong adaptability such as drought resistance, tolerance to It is resistant to pesticides and acid and alkali, and is a biosafety strain. Under the condition of reducing nitrogen fertilizer by 50% and reducing phosphorus fertilizer by 100%, field application of this inoculant can significantly increase maize plant height, above-ground and below-ground biomass, chlorophyll, leaf area index, and maize yield at different developmental stages compared with no application of control. The yields were increased by 12.56% and 7.73%, respectively, and the yield level was not significantly different from that of normal fertilization. The invention provides high-efficiency, stable growth-promoting microbial germplasm resources for the main maize planting area in my country - Northeast China, and is beneficial to promoting the green, healthy and sustainable development of my country's agriculture. The use of this bacteria can reduce the input of nitrogen fertilizer and reduce the pollution caused by excessive nitrogen fertilizer application to the environment, which is in line with the needs of sustainable green agricultural development in my country and the requirements of low-carbon, environmental protection and ecological agriculture. The invention patent expands the germplasm resources of my country's food crop growth-promoting bacteria, and provides a basis for the research and development of efficient and stable microbial fertilizers and application technologies.
保藏说明Preservation Instructions
菌株名称:芽孢杆菌Strain Name: Bacillus
拉丁名:Bacillus sp.Latin name: Bacillus sp.
参椐的生物材料(株):MGPR1Participating Biomaterial Co., Ltd.: MGPR1
保藏机构:中国微生物菌种保藏管理委员会普通微生物中心Preservation institution: General Microbiology Center of China Microorganism Culture Collection Management Committee
保藏机构简称:CGMCCAbbreviation of depositary institution: CGMCC
地址:北京市朝阳区北辰西路1号院3号Address: No. 3, Yard 1, Beichen West Road, Chaoyang District, Beijing
保藏日期:2018年12月27日Deposit date: December 27, 2018
保藏中心登记入册编号:CGMCC No.17040Depository center registration number: CGMCC No.17040
附图说明Description of drawings
图1为芽孢杆菌MGPR1在LB固体培养基上的菌落形态。Figure 1 shows the colony morphology of Bacillus MGPR1 on LB solid medium.
图2为芽孢杆菌MGPR1产IAA定性分析图。Figure 2 is a diagram showing the qualitative analysis of IAA produced by Bacillus MGPR1.
图3为IAA标准品以不同显色浓度绘制出的IAA标准曲线。Figure 3 is the IAA standard curve drawn by the IAA standard with different color development concentrations.
图4为芽孢杆菌MGPR1在解钾培养基上培养3d解钾圈图示。Figure 4 is a diagram showing the 3-d potassium-solubilizing circle of Bacillus MGPR1 cultured on a potassium-solubilizing medium.
图5为芽孢杆菌MGPR1在CAS培养基上培养3d产铁载体图示。Figure 5 is a schematic diagram of the siderophore of Bacillus MGPR1 cultured on CAS medium for 3d.
具体实施方式Detailed ways
下述实施例中所使用的实验方法如无特殊说明,均为常规方法。The experimental methods used in the following examples are conventional methods unless otherwise specified.
下述实施例中所用的材料、试剂等,如无特殊说明,均可从商业途径得到。The materials, reagents, etc. used in the following examples can be obtained from commercial sources unless otherwise specified.
实施例1、芽孢杆菌MGPR1分离和鉴定Example 1. Isolation and identification of Bacillus MGPR1
玉米在我国农业生产和发展中处于至关重要的地位,随着物质水平和科学技术的提高,玉米不再仅仅发挥作为食物原料的作用,在淀粉、制糖、榨油、酿酒,医药等领域的用途日益广泛。东北是我国玉米主要种植区之一,且东北黑土地也急需采取有效措施保护,以遏制黑土退化。本发明针对东北地区玉米生产及土壤现状,通过从玉米根际土壤中分离根际细菌并测定菌株的促生功能,如固氮、溶磷、解钾,产IAA,产铁载体,抗逆,抗病等,选出高效菌株,应用到我国玉米种植面积最大的吉林梨树的缺氮缺磷土壤长期定位试验田进行玉米大田应用效果研究,结果发现有一株菌在玉米不同生长阶段均有很好的促生效果。Corn plays a vital role in my country's agricultural production and development. With the improvement of material level and science and technology, corn no longer only plays the role of food raw materials, but also plays a role in starch, sugar, oil, wine, medicine and other fields. increasingly widespread use. Northeast my country is one of the main corn-growing areas in China, and the black soil in the northeast is in urgent need of effective protection measures to curb the degradation of the black soil. Aiming at the present situation of corn production and soil in Northeast China, the present invention isolates rhizosphere bacteria from corn rhizosphere soil and measures the growth-promoting functions of the strains, such as nitrogen fixation, phosphorus dissolution, potassium dissolution, IAA production, siderophore production, stress resistance, resistance to Diseases, etc., selected high-efficiency strains, and applied them to the long-term positioning test field of nitrogen-deficient and phosphorus-deficient soil in Jilin pear tree with the largest corn planting area in my country to study the application effect of corn field. Growth-promoting effect.
一、材料和方法1. Materials and methods
1、实验材料1. Experimental materials
(1)土壤样品的采集(1) Collection of soil samples
2017年9月15日于吉林省四平市梨树县三棵树村,采用5点采样法取玉米根际土壤,将样品混匀,放入无菌的自封袋里,于4℃冰箱保存并尽快分离。On September 15, 2017, in Sankeshu Village, Lishu County, Siping City, Jilin Province, corn rhizosphere soil was collected by the 5-point sampling method, the samples were mixed, put into a sterile ziplock bag, and stored in a refrigerator at 4°C. Separate as soon as possible.
(2)使用的培养基及试剂(2) Medium and reagents used
①LB(Luria-Bertani Agar)培养基①LB (Luria-Bertani Agar) medium
胰蛋白胨10.0g,酵母粉5.0g,NaCl 10g,琼脂15-20g(固体培养基加),去离子水1000mL,pH6.8-7.2,121℃灭菌20min。Tryptone 10.0g, yeast powder 5.0g, NaCl 10g, agar 15-20g (solid medium added), deionized water 1000mL, pH 6.8-7.2, sterilized at 121°C for 20min.
②PKO(Pikovskaya's Medium)无机磷培养基②PKO (Pikovskaya's Medium) inorganic phosphorus medium
葡萄糖10g,(NH4)2SO40.5g,NaCl 0.2g,KCl 0.2g,MgSO4·7H2O 0.03g,MnSO40.03g,FeSO40.003g,酵母膏0.5g,Ca3(PO4)25g,琼脂18g(固体培养基加),去离子水1000mL,pH6.8-7.0,121℃灭菌20min。Glucose 10g, (NH4 )2 SO4 0.5g, NaCl 0.2g, KCl 0.2g, MgSO4 ·7H2 O 0.03g, MnSO4 0.03g, FeSO4 0.003g, yeast extract 0.5g, Ca3 (PO4 )2 5g, agar 18g (solid medium added), deionized water 1000mL, pH 6.8-7.0, sterilized at 121°C for 20min.
③蒙金娜有机磷培养基③Monkina Organophosphate Medium
葡萄糖10g,(NH4)2SO4 0.5g,NaCl 0.3g,KCl 0.3g,MgSO4·7H2O 0.03g,MnSO40.03g,卵磷脂0.2g,CaCO3 5g,酵母膏0.4g,琼脂18g(固体培养基加),去离子水1000mL,pH6.8-7.2,121℃灭菌20min。Glucose 10g, (NH4 )2 SO4 0.5g, NaCl 0.3g, KCl 0.3g, MgSO4 ·7H2 O 0.03g, MnSO4 0.03g, lecithin 0.2g, CaCO3 5g, yeast extract 0.4g, agar 18 g (solid medium added), 1000 mL of deionized water, pH 6.8-7.2, sterilized at 121° C. for 20 min.
④解钾细菌培养基④ Potassium solubilizing bacteria medium
蔗糖10g,酵母膏0.5g,(NH4)2SO4 1.0g,Na2HPO4 2.0g,MgSO4·7H2O 0.5g,CaCO31.0g,钾长石粉1.0g,琼脂18g(固体培养基加),去离子水1000mL,pH6.8-7.0,121℃灭菌20min。10 g of sucrose, 0.5 g of yeast extract, 1.0 g of (NH4 )2 SO4 , 2.0 g of Na2 HPO4 , 0.5 g of MgSO4 ·7H2 O 0.5 g, 1.0 g of CaCO3 , 1.0 g of potassium feldspar powder, 18 g of agar (solid culture base plus), 1000 mL of deionized water, pH 6.8-7.0, sterilized at 121 °C for 20 min.
⑤改良YMA培养基(基础培养基)⑤ Modified YMA medium (basal medium)
甘露醇10.0g,K2HPO4 0.5g,KH2PO4 0.5g,MgSO4 0.2g,NaCl 0.1g,酵母粉1.0g,色氨酸10mg,琼脂18g(固体培养基加),去离子水1000mL,pH6.8-7.2,121℃灭菌20min。Mannitol 10.0g, K2 HPO4 0.5g, KH2 PO4 0.5g, MgSO4 0.2g, NaCl 0.1g, yeast powder 1.0g, tryptophan 10mg, agar 18g (solid medium plus), deionized water 1000mL, pH6.8-7.2, sterilized at 121℃ for 20min.
⑥CAS产铁载体培养基⑥CAS siderophore medium
溶液a:0.079g铬天青,50ml去离子水,10ml 1mmol/L的FeCl3溶液(含10微升37%(质量分数)HCl的浓盐酸(商业制剂)。Solution a: 0.079 g of chrome azure, 50 ml of deionized water, 10 ml of 1 mmol/L FeCl3 solution (concentrated hydrochloric acid (commercial preparation) containing 10 microliters of 37% (mass fraction) HCl).
溶液b:0.069g十六烷基三甲基溴化铵,40ml去离子水。Solution b: 0.069 g cetyltrimethylammonium bromide, 40 ml deionized water.
a溶液沿烧杯壁缓慢加入b溶液,摇晃混匀得CAS蓝色显色液。The solution a was slowly added to the solution b along the wall of the beaker, and the CAS blue color developing solution was obtained by shaking and mixing.
0.1mol/L磷酸缓冲液:Na2HPO4·12H2O 2.427g,NaH2PO4·2H2O 0.5905g,K2HPO40.075g,NH4Cl 0.250g,NaCl 0.125g,100ml去离子水(使用时稀释10倍)。0.1mol/L phosphate buffer: Na2 HPO4 12H2 O 2.427g, NaH2 PO4 2H2 O 0.5905g, K2 HPO4 0.075g, NH4 Cl 0.250g, NaCl 0.125g, 100ml deionized Water (diluted 10 times when using).
20%(20g/100ml)蔗糖溶液10ml,10%(10g/100ml)水解酪干素30ml,1mmol/LCaCl2 1ml,1mmol/L MgSO4 20ml,琼脂18g,0.1mol/L磷酸缓冲液和CAS蓝色显色液各50ml,121℃灭菌20min。20% (20g/100ml) sucrose solution 10ml, 10% (10g/100ml) hydrolyzed casein 30ml, 1mmol/LCaCl2 1ml, 1mmol/L MgSO4 20ml, agar 18g, 0.1mol/L phosphate buffer and CAS blue 50ml of each color developing solution, sterilized at 121℃ for 20min.
⑦血琼脂培养基⑦Blood agar medium
蛋白胨18g,酵母粉1g,NaCl 5g,琼脂15g-20g,去离子水1000mL,pH6.8-7.2。121℃灭菌20min后,待培养基冷却至50℃添加5%(5ml/100ml)脱纤维羊血,混匀后倒平板。Peptone 18g, yeast powder 1g, NaCl 5g, agar 15g-20g, deionized water 1000mL, pH 6.8-7.2. After sterilization at 121℃ for 20min, add 5% (5ml/100ml) defibrillation after the medium is cooled to 50℃ Goat blood, mixed and poured into the plate.
⑧耐盐培养基⑧Salt-tolerant medium
配制LB培养基,其中NaCl按1%、2%、3%、4%、5%、6%、7%NaCl(g/100ml)盐浓度分别称取加入,121℃灭菌20min。LB medium was prepared, wherein NaCl was added according to the salt concentration of 1%, 2%, 3%, 4%, 5%, 6% and 7% NaCl (g/100ml), respectively, and sterilized at 121°C for 20min.
⑨耐酸碱培养基⑨ Acid and alkali resistant medium
配制LB培养基7瓶,灭菌后在超静工作台中,用无菌稀盐酸和氢氧化钠溶液调整培养基的pH值分别到pH4、5、6、7、8、9、10,冷却至50℃左右倒平板。Prepare 7 bottles of LB medium. After sterilization, adjust the pH of the medium to
⑩耐农药培养基⑩Pesticide resistant medium
选取东北地区玉米常用除草剂、杀菌剂、杀虫剂各一种,按照说明书的最高使用浓度递减设4个浓度梯度,并计算出四个梯度的用量/100ml(表1)。灭菌后的LB培养基冷却至50℃左右,快速分别加入4个浓度梯度的农药量,迅速摇匀后倒平板。Select one of the commonly used herbicides, fungicides and insecticides for corn in Northeast China, set up four concentration gradients according to the maximum concentration in the instructions, and calculate the dosage of the four gradients/100ml (Table 1). The sterilized LB medium was cooled to about 50°C, and the amount of pesticides in 4 concentration gradients was quickly added, and the plate was poured after shaking quickly.
表1实验所用农药梯度设置及相应农药含量Table 1 Pesticide gradient settings and corresponding pesticide content used in the experiment
耐干旱培养基 drought tolerant medium
耐干旱培养基采用聚乙二醇(PEG 6000)调节水势人工模拟干旱条件进行耐干旱菌株鉴定。共设置4个处理,PEG 6000含量分别为:0(CK)、10%(轻度干旱)、20%(中度干旱)和30%(重度干旱)。其对应的水势分别为:0,-0.185,-0.559,-1.122MPa,121℃灭菌20min。The drought-tolerant medium was used to adjust the water potential with polyethylene glycol (PEG 6000) to artificially simulate drought conditions for identification of drought-tolerant strains. A total of 4 treatments were set, and the PEG 6000 contents were: 0 (CK), 10% (mild drought), 20% (moderate drought) and 30% (severe drought). The corresponding water potentials are: 0, -0.185, -0.559, -1.122MPa, sterilized at 121°C for 20min.
试剂 reagent
Salkowski比色液:0.5mmol/L的FeCl3溶液1ml与50ml 35%(质量分数)的高氯酸溶液(用70%(质量分数)的商业高氯酸制剂与水1:1混合配置而成)混合,显色液需现配现用,不能长时间保存。Salkowski colorimetric solution: 1mlof 0.5mmol/L FeCl3 solution and 50ml of 35% (mass fraction) perchloric acid solution (mixed with 70% (mass fraction) commercial perchloric acid preparation and water 1:1) ), the color developing solution should be prepared and used immediately and cannot be stored for a long time.
无菌生理盐水:0.8g NaCl溶于100ml去离子水中,121℃灭菌20min。Sterile physiological saline: dissolve 0.8g NaCl in 100ml deionized water, and sterilize at 121°C for 20min.
(3)使用的引物信息(3) Primer information used
如表2所示。As shown in table 2.
表2本发明所用引物信息Table 2 primer information used in the present invention
2、实验方法2. Experimental method
(1)菌株分离(1) Strain isolation
0.5g土壤样品溶于50ml 0.8%(0.8g/100ml)无菌的生理盐水中,37℃,180rpm温和摇动1h(三个样品重复)形成土壤浑浊液原液;从原液中取1ml梯度稀释至10-1、10-2、10-3、10-4、10-5,5个稀释梯度,充分摇匀获得梯度稀释液。吸取100μl上清液涂布于LB固体培养基,37℃培养至单菌落长出,挑取单菌落再平板划线纯化三次后保存。0.5g soil sample was dissolved in 50ml 0.8% (0.8g/100ml) sterile physiological saline, 37°C, 180rpm gentle shaking for 1h (repeated for three samples) to form a soil turbid liquid stock solution; take 1ml from the stock solution and dilute it to 10-1 , 10-2 , 10-3 , 10-4 , 10-5 , 5 dilution gradients, shake well to obtain gradient dilutions. Pipette 100 μl of the supernatant and spread it on LB solid medium, culture at 37° C. until a single colony grows, pick a single colony, streak and purify it three times and store it.
(2)产IAA菌株的筛选(2) Screening of IAA-producing strains
产IAA菌株定性测定:将分离纯化后的细菌接种于改良YMA液体培养基,每一菌株3个重复,摇床培养(37℃,180r/min)1d后,取50μL菌悬液滴于白色陶瓷板上,同时加入等体积的Salkowski比色液,并以加入50μL未接菌的YMA液体培养基与等体积比色液的混合溶液为对照。将白色陶瓷板于室温避光放置10min后观察,颜色变粉红者为阳性,表示能够分泌IAA,颜色越深表示分泌的强度越大,不变色为阴性,表示不能分泌IAA。Qualitative determination of IAA-producing strains: The isolated and purified bacteria were inoculated into the modified YMA liquid medium, with 3 replicates for each strain, and after culturing in a shaker (37°C, 180 r/min) for 1 day, 50 μL of bacterial suspension was dropped on a white ceramic At the same time, an equal volume of Salkowski colorimetric solution was added to the plate, and a mixed solution of 50 μL of uninoculated YMA liquid medium and an equal volume of colorimetric solution was added as a control. The white ceramic plate was placed in the dark at room temperature for 10 minutes and observed, if the color turned pink, it was positive, indicating that IAA could be secreted.
产IAA菌株定量测定:对初筛获得的能分泌IAA的细菌进行定量测定,培养条件同上。首先用分光光度法测定菌悬液的OD600值,然后将菌悬液以10000r/min离心10min取上清液加入等体积Salkowski比色液,避光静置10min,测定其OD530值。对照标准曲线计算单位体积发酵液中IAA的含量。标准曲线的绘制采用分析纯的IAA梯度稀释制备。分离得到一株产IAA含量较高的菌株,将其编号为MGPR1。Quantitative determination of IAA-producing strains: Quantitative determination of the bacteria that can secrete IAA obtained from the primary screening, the culture conditions are the same as above. First, the OD600 value of the bacterial suspension was determined by spectrophotometry, and then the bacterial suspension was centrifuged at 10,000 r/min for 10 min. The supernatant was added to an equal volume of Salkowski colorimetric solution, and the OD530 value was determined by standing in the dark for 10 min. The content of IAA in unit volume of fermentation broth was calculated according to the standard curve. Standard curves were prepared using serial dilutions of analytical grade IAA. A strain with higher IAA content was isolated and numbered as MGPR1.
(3)安全性检测(3) Security testing
将菌株MGPR1接种于血琼脂培养基中,37℃培养3d,观察有无溶血圈。有溶血圈出现代表菌株有溶血活性,对人畜有潜在威胁,则菌株应禁止应用于微生物肥料;若无溶血圈出现代表菌株无溶血活性,为安全菌种,可作为微生物肥料应用菌种。The strain MGPR1 was inoculated into blood agar medium, cultured at 37°C for 3 days, and the presence or absence of hemolytic circle was observed. If there is a hemolysis zone, it means that the strain has hemolytic activity, which is a potential threat to humans and animals, and the strain should be prohibited from being used in microbial fertilizer; if there is no hemolysis zone, it means that the strain has no hemolytic activity, which is a safe strain and can be used as a microbial fertilizer.
(4)其他功能特征筛选(4) Screening of other functional characteristics
将菌株MGPR1接种于PKO无机磷培养基,蒙金娜有机磷培养基,解钾培养基以及CAS产铁载体培养基中,37℃培养3d,若菌体四周出现透明圈或晕圈,则表明菌株有相关的促生特性;若无透明或晕圈,则表明菌株无相应能力。The strain MGPR1 was inoculated into PKO inorganic phosphorus medium, Montkina organic phosphorus medium, potassium solution medium and CAS siderophore medium, and cultured at 37°C for 3 days. The strain has relevant growth-promoting properties; if there is no transparency or halo, the strain is incompetent.
(5)抗逆性检测(5) Stress resistance detection
将菌株MGPR1接于耐盐、耐酸碱培养基中,37℃培养3d,观察细菌生长情况。The strain MGPR1 was inoculated in salt-tolerant, acid- and alkali-resistant medium, cultured at 37°C for 3 days, and the bacterial growth was observed.
(6)耐干旱(6) Drought resistance
将菌株MGPR1接于耐干旱培养基中,37℃培养3d,观察细菌生长情况。The strain MGPR1 was inoculated into a drought-resistant medium, cultured at 37°C for 3 days, and the bacterial growth was observed.
(7)耐药性(7) Drug resistance
将菌株MGPR1接于耐农药培养基中,37℃培养3d,观察细菌生长情况。The strain MGPR1 was inoculated into the pesticide-resistant medium, cultured at 37°C for 3 days, and the bacterial growth was observed.
(8)16s rDNA序列测序鉴定(8) Identification of 16s rDNA sequence sequencing
利用TreliefTM Plant Genomic DNA kit(TsingKe)试剂盒提取菌体DNA,并对16srDNA序列进行PCR扩增,所用正向引物为16s rDNA P1,反向引物为16s rDNA P6。扩增反应条件为:95℃5min;94℃1min,60℃30s,72℃90s,进行30个循环;最后72℃终延伸10min。PCR扩增产物检测合格后送至北京美吉桑格生物医药科技有限公司进行测序。The bacterial DNA was extracted by TreliefTM Plant Genomic DNA kit (TsingKe), and the 16s rDNA sequence was amplified by PCR. The forward primer used was 16s rDNA P1 and the reverse primer was 16s rDNA P6. Amplification reaction conditions were: 95°C for 5 min; 94°C for 1 min, 60°C for 30 s, 72°C for 90 s, 30 cycles; and a final extension at 72°C for 10 min. PCR amplification products were sent to Beijing Meiji Sanger Biomedical Technology Co., Ltd. for sequencing.
二、结果分析2. Analysis of the results
1、菌株基本特征1. Basic characteristics of strains
菌株MGPR1接种于LB液体培养基,37℃,180r/min的培养箱中振荡培养24-36小时,该菌株可产芽孢;在LB固体培养基37℃恒温培养48h,观察其菌落形态,菌落呈淡黄色,圆形,表面光滑不透明,边缘缺刻,有时微皱;革兰氏染色为阳性,菌体杆状,具有端生鞭毛,运动,无夹膜,芽孢中生,椭圆形(图1)。Strain MGPR1 was inoculated in LB liquid medium and cultured in a 37°C, 180r/min incubator with shaking for 24-36 hours. The strain could produce spores; it was incubated in LB solid medium at 37°C for 48h at a constant temperature, and the colony morphology was observed. Pale yellow, round, smooth and opaque surface, notched edges, sometimes slightly wrinkled; Gram-positive, rod-shaped, with terminal flagella, motile, no encapsulation, spores mesogenic, oval (Figure 1) .
2、安全性检测结果2. Safety test results
菌株MGPR1在血琼脂平板上培养3d,不出现溶血圈,溶血活性为阴性。Strain MGPR1 was cultured on blood agar plate for 3 days, no hemolytic circle appeared, and the hemolytic activity was negative.
3、功能特征结果3. Functional characteristics results
功能特征鉴定结果如表3所示。芽孢杆菌MGPR1产IAA定性分析图如图2所示。IAA标准品以不同显色浓度绘制出的IAA标准曲线如图3所示。芽孢杆菌MGPR1在解钾培养基上培养3d解钾圈图示如图4所示。芽孢杆菌MGPR1在CAS培养基上培养3d产铁载体图示如图5所示。The results of functional feature identification are shown in Table 3. Figure 2 shows the qualitative analysis of IAA produced by Bacillus MGPR1. The IAA standard curve drawn by the IAA standard with different color development concentrations is shown in Figure 3. Figure 4 shows the diagram of the potassium-solubilizing circle of Bacillus MGPR1 cultured on the potassium-solubilizing medium for 3 days. Figure 5 shows the siderophore diagram of Bacillus MGPR1 cultured on CAS medium for 3d.
表3菌株MGPR1的功能特征鉴定结果Table 3 Identification results of functional characteristics of strain MGPR1
注:+号表示阳性;-号表示阴性;+号越多代表能力越强;—表示未测。Note: + means positive; - means negative; more + means stronger ability; - means not tested.
4、抗逆性结果4. Stress resistance results
如表4所示。As shown in Table 4.
表4菌株MGPR1的抗逆性鉴定结果Table 4. Results of stress resistance identification of strain MGPR1
注:+表示菌株生长;-表示菌株未生长;++代表菌株生长情况比+更好。Note: + means that the strain grows; - means that the strain does not grow; ++ means that the growth of the strain is better than +.
5、耐药性结果5. Drug resistance results
如表5所示。As shown in Table 5.
表5菌株MGPR1的耐药性鉴定结果Table 5 Results of drug resistance identification of strain MGPR1
注:+表示菌株生长;-表示菌株未生长;+号越多代表菌株生长情况越好。Note: + means that the strain is growing; - means that the strain is not growing; the more + signs, the better the growth of the strain.
6、菌株16s rDNA序列测序结果6. Sequencing results of strain 16s rDNA sequence
双端测序序列用DNAMAN软件进行拼接,共1456bp,核苷酸序列如SEQ ID No.1所示。得到的16s rDNA序列(SEQ ID No.1)在NCBI网站进行BLAST比对,结果显示该菌株与Bacillus megaterium strain NPJ1相似性最高,同源性为100%。The paired-end sequencing sequence was spliced with DNAMAN software, with a total of 1456 bp, and the nucleotide sequence is shown in SEQ ID No.1. The obtained 16s rDNA sequence (SEQ ID No. 1) was compared by BLAST on the NCBI website, and the results showed that the strain had the highest similarity with Bacillus megaterium strain NPJ1, and the homology was 100%.
鉴于以上对菌株MGPR1的鉴定结果,确定该菌为芽孢杆菌属(Bacillus sp.)。将该菌株于2018年12月27日保藏于中国普通微生物菌种保藏管理中心,其保藏编号为CGMCCNo.17040。In view of the above identification results of the strain MGPR1, the strain was determined to be Bacillus sp. The strain was deposited in the China General Microorganism Culture Collection and Management Center on December 27, 2018, and its deposit number is CGMCCNo.17040.
实施例2、芽孢杆菌MGPR1的田间应用Example 2. Field application of Bacillus MGPR1
一、芽孢杆菌MGPR1的田间应用方法1. Field application of Bacillus MGPR1
1、菌株活化及扩大培养:将保藏于-80℃冰箱的芽孢杆菌(Bacillus sp.)MGPR1CGMCC No.17040菌种采用三区划线方式活化于LB固体培养基,放于37℃恒温培养箱培养24小时,分离单菌落。将单菌落用无菌竹签挑至添加色氨酸(0.1mg/ml,作用:合成IAA的底物)的LB液体培养基中扩大培养,放于37℃,180转/分的摇床振荡培养至菌液OD600=1.5(以不接菌培养基为空白对照,菌液浓度为1×1010-11cfu/ml);1. Bacterial activation and expanded culture: The Bacillus sp. MGPR1CGMCC No.17040 strain stored in a -80°C refrigerator was activated in LB solid medium by a three-zone streak method, and placed in a 37°C constant temperature incubator for cultivation. After 24 hours, single colonies were isolated. Pick a single colony with a sterile bamboo skewer into the LB liquid medium supplemented with tryptophan (0.1 mg/ml, role: substrate for synthesizing IAA) to expand the culture, and place it at 37 ° C and shake at 180 rpm on a shaker. Cultivated to bacterial liquid OD600 =1.5 (taking no inoculated medium as blank control, bacterial liquid concentration was 1×1010-11 cfu/ml);
2、使用前在菌剂中滴加微量元素(1μL/ml,作用:增加营养提高细菌活性)混匀。微量元素液组成如下:H3BO3 2.86g/L,MnSO4 1.81g/L,CuSO4·5H2O 0.80g/L,ZnSO4 0.22g/L,H2MoO4 0.02g/L,将以上物品依次加入适量水中全部溶解后,用去离子水补足1L。2. Add trace elements (1μL/ml, function: increase nutrition and improve bacterial activity) in the bacterial agent before use and mix well. The composition of the trace element liquid is as follows: H3 BO3 2.86g/L, MnSO4 1.81g/L, CuSO4 ·5H2 O 0.80g/L, ZnSO4 0.22g/L, H2 MoO4 0.02g/L, the The above items are added to the appropriate amount of water in order to dissolve all, and then make up to 1L with deionized water.
3、包菌剂:将混匀的菌液均匀喷在种子表面至种子表面湿润即可,放在阴凉处阴干;3. Bacterial agent: evenly spray the mixed bacterial solution on the surface of the seeds until the surface of the seeds is wet, and place them in a cool place to dry in the shade;
4、包保护剂:阴干的种子用1%的羧甲基纤维素钠溶液(配制方法:10g羧甲基纤维素钠(800~1200mPa·s)溶于1L去离子水,在60℃水浴中搅拌溶解至透明糊状胶液)拌种包衣(50ml/kg),保持菌剂附着和湿度,阴干;4. Packing protective agent: The seeds dried in the shade are dissolved in 1L deionized water with 1% sodium carboxymethyl cellulose solution (preparation method: 10g sodium carboxymethyl cellulose (800~1200mPa·s), in a water bath at 60°C Stir and dissolve to transparent paste glue) seed dressing coating (50ml/kg), keep bacterial agent adhesion and humidity, dry in the shade;
5、人工或机器播种(建议播后浇水,保证菌株必要的湿度利于生存)。5. Sowing by hand or machine (it is recommended to water after sowing to ensure the necessary humidity for the strain to survive).
二、芽孢杆菌MGPR1田间应用实例2. Field application example of Bacillus MGPR1
试验地点设在吉林省四平市梨树县三棵树村;所选用玉米品种为当地普遍使用的品种郑单958;播种日期为2018年4月30日,播后浇水(即2018年5月1日浇水);试验田分为三部分,低氮区、缺磷区和正常施肥区。氮磷区各850.5平方米,正常施肥区56.7平方米。低氮区施氮肥为尿素,施用量是正常施肥的一半,120kg N ha-1;磷肥为过磷酸钙,正常施用量为85kg P2O5ha-1;钾肥为氯化钾,正常施用量为67.5kg K2Oha-1,全部作为基肥混匀后一次性施入土壤;缺磷区不施磷肥,氮钾肥为正常施用量(同上);正常施肥区正常施肥,不做接种生物菌剂处理,为阳性对照区CK+。其他两个肥料处理区都做接种生物菌剂处理,所用生物菌剂为芽孢杆菌(Bacillus sp.)MGPR1CGMCC No.17040。设不接种为阴性对照CK-,每种处理三个重复。The test site is located in Sankeshu Village, Lishu County, Siping City, Jilin Province; the selected corn variety is Zhengdan 958, a commonly used local variety; the sowing date is April 30, 2018, and watering after sowing (ie, May 2018) 1 day watering); the experimental field is divided into three parts, low nitrogen area, phosphorus deficiency area and normal fertilization area. The nitrogen and phosphorus areas are 850.5 square meters each, and the normal fertilization area is 56.7 square meters. The nitrogen fertilizer applied in the low nitrogen area is urea, and the application amount is half of the normal fertilizer application, 120kg N ha-1 ; the phosphate fertilizer is superphosphate, and the normal application amount is 85kg P2 O5 ha-1 ; the potassium fertilizer is potassium chloride, the normal application amount It is 67.5kg K2 Oha-1 , all of which are mixed as base fertilizer and applied to the soil at one time; no phosphorus fertilizer is applied in the phosphorus-deficient area, and nitrogen and potassium fertilizer is the normal application amount (same as above); the normal fertilization area is fertilized normally, and no biological inoculum is used. treatment, as the positive control area CK+ . The other two fertilizer treatment areas were inoculated with biological inoculants, and the biological inoculants used were Bacillus sp. MGPR1CGMCC No.17040. The negative control CK- was set without inoculation, and each treatment was replicated in triplicate.
筛选结果为芽孢杆菌(Bacillus sp.)MGPR1CGMCC No.17040在玉米不同生长发育阶段均可提高玉米植株的生物量以及最终产量,该菌促生效果显著高于CK-,且与阳性对照CK+无显著差异,田间实验结果进一步证明此芽孢杆菌MGPR1可作为开发稳定高效的微生物肥料菌种资源。具体结果如表6至表9所示(表中同列标注不同字母表示彼此之间差异显著):The screening result is that Bacillus sp.MGPR1CGMCCNo.17040 can increase the biomass and final yield of maize plants at different growth and development stages of maize. Significant differences, the results of field experiments further proved that this Bacillus MGPR1 can be used as a resource for developing stable and efficient microbial fertilizers. The specific results are shown in Tables 6 to 9 (different letters in the same column indicate significant differences between each other):
表6应用MGPR1菌剂玉米苗期生物量一览表Table 6 List of biomass in corn seedling stage using MGPR1 inoculum
表7应用MGPR1菌剂玉米拔节期生物量一览表Table 7 List of corn jointing stage biomass using MGPR1 inoculum
表8应用MGPR1菌剂玉米吐丝期生物量一览表Table 8 List of biomass in corn silking stage using MGPR1 inoculum
表9应用MGPR1菌剂玉米成熟期生物量一览表Table 9 List of biomass at maturity of maize using MGPR1 inoculant
<110> 中国农业大学<110> China Agricultural University
<120> 一株能减少氮磷肥施用的玉米高效促生菌及其应用<120> A high-efficiency maize growth-promoting bacterium that can reduce nitrogen and phosphorus fertilizer application and its application
<130> GNCLN190311<130> GNCLN190311
<160> 1<160> 1
<170> PatentIn version 3.5<170> PatentIn version 3.5
<210> 1<210> 1
<211> 1456<211> 1456
<212> DNA<212> DNA
<213> Bacillus sp.<213> Bacillus sp.
<400> 1<400> 1
ggggcgggcg tgcctataca tgcagtcgag cgaactgatt agaagcttgc ttctatgacg 60ggggcgggcg tgcctataca tgcagtcgag cgaactgatt agaagcttgc ttctatgacg 60
ttagcggcgg acgggtgagt aacacgtggg caacctgcct gtaagactgg gataacttcg 120ttagcggcgg acgggtgagt aacacgtggg caacctgcct gtaagactgg gataacttcg 120
ggaaaccgaa gctaataccg gataggatct tctccttcat gggagatgat tgaaagatgg 180ggaaaccgaa gctaataccg gataggatct tctccttcat gggagatgat tgaaagatgg 180
tttcggctat cacttacaga tgggcccgcg gtgcattagc tagttggtga ggtaacggct 240tttcggctat cacttacaga tgggcccgcg gtgcattagc tagttggtga ggtaacggct 240
caccaaggca acgatgcata gccgacctga gagggtgatc ggccacactg ggactgagac 300caccaaggca acgatgcata gccgacctga gagggtgatc ggccacactg ggactgagac 300
acggcccaga ctcctacggg aggcagcagt agggaatctt ccgcaatgga cgaaagtctg 360acggcccaga ctcctacggg aggcagcagt agggaatctt ccgcaatgga cgaaagtctg 360
acggagcaac gccgcgtgag tgatgaaggc tttcgggtcg taaaactctg ttgttaggga 420acggagcaac gccgcgtgag tgatgaaggc tttcgggtcg taaaactctg ttgttaggga 420
agaacaagta caagagtaac tgcttgtacc ttgacggtac ctaaccagaa agccacggct 480agaacaagta caagagtaac tgcttgtacc ttgacggtac ctaaccagaa agccacggct 480
aactacgtgc cagcagccgc ggtaatacgt aggtggcaag cgttatccgg aattattggg 540aactacgtgc cagcagccgc ggtaatacgt aggtggcaag cgttatccgg aattattggg 540
cgtaaagcgc gcgcaggcgg tttcttaagt ctgatgtgaa agcccacggc tcaaccgtgg 600cgtaaagcgc gcgcaggcgg tttcttaagt ctgatgtgaa agcccacggc tcaaccgtgg 600
agggtcattg gaaactgggg aacttgagtg cagaagagaa aagcggaatt ccacgtgtag 660agggtcattg gaaactgggg aacttgagtg cagaagagaa aagcggaatt ccacgtgtag 660
cggtgaaatg cgtagagatg tggaggaaca ccagtggcga aggcggcttt ttggtctgta 720cggtgaaatg cgtagagatg tggaggaaca ccagtggcga aggcggcttt ttggtctgta 720
actgacgctg aggcgcgaaa gcgtggggag caaacaggat tagataccct ggtagtccac 780actgacgctg aggcgcgaaa gcgtggggag caaacaggat tagataccct ggtagtccac 780
gccgtaaacg atgagtgcta agtgttagag ggtttccgcc ctttagtgct gcagctaacg 840gccgtaaacg atgagtgcta agtgttagag ggtttccgcc ctttagtgct gcagctaacg 840
cattaagcac tccgcctggg gagtacggtc gcaagactga aactcaaagg aattgacggg 900cattaagcac tccgcctggg gagtacggtc gcaagactga aactcaaagg aattgacggg 900
ggcccgcaca agcggtggag catgtggttt aattcgaagc aacgcgaaga accttaccag 960ggcccgcaca agcggtggag catgtggttt aattcgaagc aacgcgaaga accttaccag 960
gtcttgacat cctctgacaa ctctagagat agagcgttcc ccttcggggg acagagtgac 1020gtcttgacat cctctgacaa ctctagagat agagcgttcc ccttcggggg acagagtgac 1020
aggtggtgca tggttgtcgt cagctcgtgt cgtgagatgt tgggttaagt cccgcaacga 1080aggtggtgca tggttgtcgt cagctcgtgt cgtgagatgt tgggttaagt cccgcaacga 1080
gcgcaaccct tgatcttagt tgccagcatt tagttgggca ctctaaggtg actgccggtg 1140gcgcaaccct tgatcttagt tgccagcatt tagttgggca ctctaaggtg actgccggtg 1140
acaaaccgga ggaaggtggg gatgacgtca aatcatcatg ccccttatga cctgggctac 1200acaaaccgga ggaaggtggg gatgacgtca aatcatcatg ccccttatga cctgggctac 1200
acacgtgcta caatggatgg tacaaagggc tgcaagaccg cgaggtcaag ccaatcccat 1260acacgtgcta caatggatgg tacaaagggc tgcaagaccg cgaggtcaag ccaatcccat 1260
aaaaccattc tcagttcgga ttgtaggctg caactcgcct acatgaagct ggaatcgcta 1320aaaaccattc tcagttcgga ttgtaggctg caactcgcct acatgaagct ggaatcgcta 1320
gtaatcgcgg atcagcatgc cgcggtgaat acgttcccgg gccttgtaca caccgcccgt 1380gtaatcgcgg atcagcatgc cgcggtgaat acgttcccgg gccttgtaca caccgcccgt 1380
cacaccacga gagtttgtaa cacccgaagt cggtgagtaa ccgtaaggag ctagccgcct 1440cacaccacga gagtttgtaa cacccgaagt cggtgagtaa ccgtaaggag ctagccgcct 1440
aaggtgacag aagaat 1456aaggtgacag aagaat 1456
Claims (15)
Priority Applications (1)
| Application Number | Priority Date | Filing Date | Title |
|---|---|---|---|
| CN201910150243.6ACN109679884B (en) | 2019-02-28 | 2019-02-28 | A high-efficiency maize growth-promoting bacterium that can reduce nitrogen and phosphorus fertilizer application and its application |
Applications Claiming Priority (1)
| Application Number | Priority Date | Filing Date | Title |
|---|---|---|---|
| CN201910150243.6ACN109679884B (en) | 2019-02-28 | 2019-02-28 | A high-efficiency maize growth-promoting bacterium that can reduce nitrogen and phosphorus fertilizer application and its application |
Publications (2)
| Publication Number | Publication Date |
|---|---|
| CN109679884A CN109679884A (en) | 2019-04-26 |
| CN109679884Btrue CN109679884B (en) | 2020-09-25 |
Family
ID=66197012
Family Applications (1)
| Application Number | Title | Priority Date | Filing Date |
|---|---|---|---|
| CN201910150243.6AActiveCN109679884B (en) | 2019-02-28 | 2019-02-28 | A high-efficiency maize growth-promoting bacterium that can reduce nitrogen and phosphorus fertilizer application and its application |
Country Status (1)
| Country | Link |
|---|---|
| CN (1) | CN109679884B (en) |
Families Citing this family (7)
| Publication number | Priority date | Publication date | Assignee | Title |
|---|---|---|---|---|
| CN110229764B (en)* | 2019-05-27 | 2022-09-16 | 广州大学 | Bacillus belgii YC666 and application thereof |
| CN110257283B (en)* | 2019-06-14 | 2021-08-06 | 中国农业大学 | A Resistant and Nitrogen-fixing Brachyrhizobia Suitable for Huanghuai District and Its Application |
| CN110590417B (en)* | 2019-08-01 | 2021-12-17 | 宁夏医科大学 | Bacillus pumilus bacterial fertilizer and application thereof |
| CN110468073B (en)* | 2019-08-20 | 2021-08-24 | 中国农业大学 | A Stress-resistant Nitrogen-fixing Brachyrhizobia suitable for Northeast China and its application |
| CN115287227B (en)* | 2022-07-26 | 2023-11-10 | 中国农业大学 | Bacillus for promoting nitrogen nutrition and growth of plants and application thereof |
| CN116716374A (en)* | 2023-06-06 | 2023-09-08 | 西南大学 | Screening of an efficient phosphate-solubilizing bacterium producing indoleacetic acid and verification of its growth-promoting effect |
| CN116790426B (en)* | 2023-06-16 | 2024-02-13 | 西南大学 | Flavobacterium strain for reducing application of plant phosphate fertilizer and application thereof |
Family Cites Families (10)
| Publication number | Priority date | Publication date | Assignee | Title |
|---|---|---|---|---|
| CN104263684B (en)* | 2014-09-25 | 2016-11-23 | 山东农业大学 | A kind of product siderophore series bacillus and application thereof |
| CN104560785A (en)* | 2014-12-13 | 2015-04-29 | 郑州市污水净化有限公司 | Corn growth-promoting rhizobacteria YM11 and application thereof |
| CN104630087B (en)* | 2014-12-13 | 2018-05-01 | 河南农业大学 | A kind of Rhizosphere of Crops Promoting bacteria YM4 and its application |
| CN104560786A (en)* | 2014-12-13 | 2015-04-29 | 郑州市污水净化有限公司 | Maize root growth-promoting bacterium YM6 and application thereof |
| CN104630090B (en)* | 2014-12-13 | 2018-04-17 | 河南农业大学 | A kind of Rhizosphere of Crops Promoting bacteria YM3 and its application |
| CN104805045B (en)* | 2015-05-05 | 2017-12-19 | 中国科学院烟台海岸带研究所 | Plant growth-promoting rhizobacteria and its application |
| CN105670961B (en)* | 2016-01-22 | 2018-11-20 | 广西大学 | It is a kind of solve Phos plant growth-promoting bacterial strain NG-33 and its application |
| WO2017184810A1 (en)* | 2016-04-21 | 2017-10-26 | Koch Agronomic Services, Llc | Microbial inoculant compositions and uses thereof |
| CN107384840B (en)* | 2017-09-07 | 2020-01-07 | 北京农业生物技术研究中心 | Drought-resistant growth-promoting compound microbial inoculum and application thereof |
| CN108660098B (en)* | 2018-07-04 | 2021-04-30 | 山东农业大学 | Salt-tolerant disease-preventing growth-promoting bacillus subtilis and preparation and application of microbial inoculum thereof |
- 2019
- 2019-02-28CNCN201910150243.6Apatent/CN109679884B/enactiveActive
Also Published As
| Publication number | Publication date |
|---|---|
| CN109679884A (en) | 2019-04-26 |
Similar Documents
| Publication | Publication Date | Title |
|---|---|---|
| CN109679884B (en) | A high-efficiency maize growth-promoting bacterium that can reduce nitrogen and phosphorus fertilizer application and its application | |
| US12382961B2 (en) | Methods and compositions for improving corn yield | |
| US20250169503A1 (en) | Bacillus velezensis and use thereof | |
| CN106164247A (en) | Inoculation microbial inoculum for stress soil | |
| CN103103150B (en) | Efficient phosphate solubilizing growth-promoting bacteria and microbial agent prepared from same and application | |
| Jat et al. | Microbiome for sustainable agriculture: a review with special reference to the corn production system | |
| AU2013351876B2 (en) | Phosphate solubilizing rhizobacteria Bacillus firmus as biofertilizer to increase canola yield | |
| US10000427B2 (en) | Phosphate solubilizing rhizobacteria bacillus firmus as biofertilizer to increase canola yield | |
| CN111269859B (en) | Corn rhizosphere growth-promoting bacterium with phosphorus dissolving, growth promoting and strong adaptability and application thereof | |
| Pallavi et al. | Commercial microbial products: exploiting beneficial plant-microbe interaction | |
| CN103651582B (en) | Broad-spectrum composite microbial fungicide and preparation method thereof | |
| RU2595405C1 (en) | STRAINS OF BACTERIA Bacillus, Pseudomonas, Rahnella, Serratia HAVING PHYTOPROTECTIVE AND GROWTH-STIMULATING ACTIVITY, AND PREPARATION BASED ON SAID STRAINS | |
| Rashid et al. | Biofertilizer use for sustainable agricultural production | |
| VVafaa | Sustainable agriculture management of plant diseases | |
| Yadav et al. | Endophytes and their applications as biofertilizers | |
| Sharma et al. | Microbial inoculants: Recent progress in formulations and methods of application | |
| Sanyal et al. | Influence of cyanobacterial inoculants, elevated carbon dioxide, and temperature on plant and soil nitrogen in soybean | |
| CA2845408C (en) | Phosphate solubilizing rhizobacteria bacillus firmus as biofertilizer to increase canola yield | |
| Walia et al. | Techniques for improving microbial inoculants as a tool for sustainable development | |
| CN111909863B (en) | A strain of Bacillus amyloliquefaciens and its use | |
| CN107227270B (en) | Biological control microbial inoculum for soil-borne diseases, biological control substrate for soil-borne diseases, and preparation method and use method thereof | |
| WO2016181216A1 (en) | Pgpr compositions and methods for improved cultivation of tomato and potato species | |
| CN116918832A (en) | Composite biocontrol microbial agent, preparation method, application and application method | |
| CN108998395A (en) | A kind of bacillus amyloliquefaciens and application thereof | |
| CN110628685B (en) | Bacillus subtilis strain and application thereof in agricultural production |
Legal Events
| Date | Code | Title | Description |
|---|---|---|---|
| PB01 | Publication | ||
| PB01 | Publication | ||
| SE01 | Entry into force of request for substantive examination | ||
| SE01 | Entry into force of request for substantive examination | ||
| GR01 | Patent grant | ||
| GR01 | Patent grant |